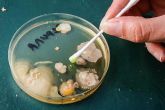
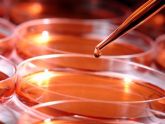

Рубрика "Чистый барьер"
2-3/2022 (88-89) март-июнь
- Важность качества поверхностей: характеристики фармацевтического оборудования и адгезия микроорганизмов

Важным фактором при выборе оборудования для чистых помещений является обработка и шероховатость поверхности, особенно когда речь идет о нержавеющей стали, учитывая частоту использования этого материала, как и анодированного алюминия, при изготовлении фармацевтического технологического оборудования.
- Идентификация микробных изолятов, выделенных из окружающей среды

Кроме обнаружения и подсчета количества микроорганизмов в исследуемой пробе окружающей среды (например, в воздухе, в сжатом воздухе, в очищенной воде и на поверхностях оборудования), важно идентифицировать репрезентативные микробные изоляты, извлеченные из окружающей среды, для отслеживания изменений в тенденциях. Изменения в микрофлоре, обнаруживаемой в пробе окружающей среды, могут свидетельствовать об отклонении от нормы.
1/2022 (87) январь-февраль
- Сохранение стерильности в асептической технологии

Системы быстрой передачи – популярный способ перемещения предметов в эпоху, когда системы герметизации стали особенно необходимы.
- Влияние санитарной одежды на чистоту производственной среды

В настоящей статье коллеги из университетских больниц Бристоля и Уэстона (University Hospitals Bristol and Weston - UHBW) доверительного фонда Национальной службы здравоохранения рассказывают о положительном влиянии улучшения элементов оснащения и процедур на снижение уровня загрязнения среды чистых помещений.
- Обзор метода определения герметичности упаковки трассирующей жидкостью

В современной фармацевтической промышленности необходимо подтверждать целостность первичной упаковки. Для стерильных лекарственных средств это требование напрямую влияет на качество и гарантирует сохранение стерильности содержимого.
- Разработка фильтр-вентиляционных модулей

Фильтр-вентиляционные модули (ФВМ, Fan Filter Unit - FFU) имеют особые преимущества для пользователей чистых помещений. Роб Флаэрти, специалист по ФВМ (компания Swegon), рассматривает эволюцию применения ФВМ в чистых помещениях, а также перспективы внедрения новых ФВМ с низким потреблением энергии.
6/2021 (86) ноябрь-декабрь
- Как установить стальную дверь для чистого помещения

Специалисты по строительству чистых помещений компании Wiskind описывают процесс установки стальной двери в девять этапов.
- Облучение вирусных патогенов невидимым светом: стратегии борьбы с вирусным заражением с использованием излучения УФ-С

Коронавирусная инфекция всё ещё вызывает беспокойство при контроле строительства и проектирования (в том числе при контроле чистых помещений и других зон в фармацевтических и медицинских учреждениях). Коронавирусная инфекция 2 (SARS-CoV-2), являющаяся возбудителем тяжёлого острого респираторного синдрома, представляет собой оболочечный одноцепочечный РНК-вирус семейства Coronaviridae отряда Nidovirales.
- Стратегия контроля загрязнений – новый акцент в обучении персонала

В связи с предстоящим внедрением пересмотренного Приложения 1 к GMP Европейского Союза многие компании разрабатывают стратегии контроля загрязнений. Для некоторых это новый опыт, поскольку требования применяются как к стерильным, так и к нестерильным производствам.
- Основы проектирования и испытаний передаточных боксов. Разбор основ адекватного контроля загрязнений

Одной из распространённых задач при проектировании и эксплуатации предприятия является организация перемещения персонала и материалов в чистые помещения и из них. Перемещение подразумевает переход от одного уровня чистоты к другому, так как осуществляется между отдельными помещениями.
5/2021 (85) сентябрь-октябрь
- Татуировки, пирсинг, загар: альтернативные риски для чистых помещений

Исторически в разных культурах практиковались всевозможные способы модификации (изменения) человеческого тела: загар, пирсинг ушей, татуаж, косметическая хирургия. Сегодня эти практики по-прежнему популярны, особенно в молодежной среде, и несут в себе угрозы здоровью, в том числе микробиологические риски, о которых и говорится в настоящей статье...
- Оценка эффективности дезинфицирующих средств с помощью внутренних изолятов микроорганизмов

Повседневно используемые дезинфицирующие средства должны обладать эффективностью в отношении обычной микрофлоры, присутствующей в помещениях… При необходимости связанные с неблагоприятными тенденциями микроорганизмы могут исследоваться на предмет чувствительности к дезинфицирующим средствам, применяемым в чистом помещении.
4/2021 (84) июль-август
- Использование боксов биологической безопасности в условиях cGMP

Производство эффективных лекарственных средств, не содержащих вредных загрязняющих веществ, зависит от способности производственного предприятия поддерживать асептическую среду. В то время, как некоторые лекарственные средства подвергаются финишной тепловой или газовой стерилизации, такой подход может быть губительным для биологических продуктов. Вместо этого качество и безопасность биологических продуктов достигается с помощью строго регулируемых асептических сред, которые...
- Компоненты эффективной стратегии предварительной квалификации дезинфицирующих средств
Микробиологический контроль на фармацевтических предприятиях необходим для обеспечения производства безопасных и высококачественных лекарств, а важными компонентами любой стратегии микробиологического контроля являются процедуры очистки, разработанные специально для удаления возможных микробных загрязнений.
3/2021 (83) май-июнь
- Не все средства индивидуальной защиты одинаковы

Компания ASAP Innovations рассказывает о стоимости фальшивых средств индивидуальной защиты (СИЗ) и о том, как продавцы и покупатели могут распознать поддельные изделия.
- Как развиваются гибкие плёночные изоляторы?

В контексте быстрого развития современной фармацевтической отрасли «гибкость» плёночных изоляторов является реальным достоинством. Их эксплуатационные испытания при работе с АФС и высокоактивными АФС (ВААФС) демонстрируют, что, с точки зрения защиты оператора, они в состоянии конкурировать с жёсткими конструкциями.
- НЕРА-фильтры: риски, связанные с закупкой и эксплуатацией

Любому фармацевтическому предприятию (и предприятиям), изготавливающим первичную упаковку для лекарственных препаратов, приходится сталкиваться с закупкой и установкой НЕРА-фильтров при строительстве новых производственных зданий, во время квалификации комплекса чистых помещений при замене вышедших из строя фильтров.
2/2021 (82) март-апрель
- Ещё о проблемах выполнения процедуры очистки

Специалисты, ответственные за контроль качества и (или) валидацию, выявляют ряд проблем ручной очистки фармацевтического производственного оборудования. Идентифицированы три обобщенные категории проблем...
- Роль дезинфицирующих средств и антисептиков в загрязнении чистых помещений

Известно, что основными источниками поступления микроорганизмов в чистые производственные помещения являются: персонал, воздух, вода, оборудование, сырьё, упаковочные материалы, однако применение загрязненных дезинфицирующих средств и антисептиков также может привести к загрязнению производимой продукции и распространению штаммов, устойчивых к используемым химическим биоцидным веществам...
1/2021 (81) январь-февраль
- Облучение ультрафиолетовым излучением - как способ дезинфицирующей обработки производственных зон

С середины прошлого века бактерицидные свойства ультрафиолетового излучения активно используются не только в медицинских целях, но и во всех отраслях экономики...
- Путь развития барьерных технологий

Более двух десятилетий Международная ассоциация фармацевтического инжиниринга (ISPE), собирая значимые данные о применении барьерных технологий в рамках исследования «ISPE Barrier Isolator Survey», служила источником информации для фармпроизводителей, занимающихся фасовкой и упаковкой...
- Влияние меняющихся знаний микробиолога на эффективность программы контроля загрязнений

Сейчас в отрасли повсеместно внедряются комплексные программы контроля микробиологических загрязнений, основанные на оценке рисков, - как средство повышения безопасности пациентов и улучшения действующей стратегии контроля технологического процесса и качества выпускаемой продукции...
6/2020 (80) ноябрь-декабрь
- Удаление остатков дезинфицирующих средств согласно Приложению 1 GMP

Карен Россингтон (корпорация Contec) анализирует широко используемые в чистых помещениях дезинфицирующие средства, чтобы прояснить лучший способ удаления их остатков с поверхностей.
- Предотвращение загрязнения при производстве биофармацевтических препаратов

Исследование, в ходе которого были проанализированы связанные с обеспечением качества и с контролем качества случаи на нескольких биофармацевтических предприятиях, показало, как компании могут наилучшим образом выявлять вирусное загрязнение и смягчать его последствия.
- Эффективность HEPA-фильтров при удалении вирусов из воздуха, поступающего в чистые помещения

Удаление или уничтожение вирусов является важнейшим элементом при производстве отдельных лекарственных препаратов...
5/2020 (79) сентябрь-октябрь
- Минимизация выживания микроорганизмов на поверхностях чистых помещений

Мониторинг микробиологической чистоты в чистых помещениях в основном проводят в соответствии со стандартами – с использованием культивации, контактных пластин или ватных палочек. Хорошо известно, что методы мониторинга производственной среды ограничены в своей способности восстанавливать микроорганизмы с поверхности из-за ограничений самих методов, селективности питательных сред и времени инкубации, а также из-за сложностей, связанных с поверхностным сцеплением микроорганизмов, присутствия активных, но не пригодных для культивации микроорганизмов.
- Проблемы выполнения процедуры очистки

Специалисты по валидации и качеству выявили целый ряд проблем с ручной очисткой фармацевтического производственного оборудования. В данной статье представлены актуальные проблемы с корректирующими и предупреждающими действиями (Corrective and Preventive Actions, CAPA).
- Очистка и дезинфекция помещений с помощью аэрозолей и/или тумана дезинфицирующих средств

Очистке и дезинфекции после производственного процесса подвергаются только поверхности, контактирующие с пищевыми продуктами, что может привести к выживанию микроорганизмов в производственной среде в целом.
4/2020 (78) июль-август
- Санитарно-гигиенические требования при проектировании фармацевтических производств

Важной целью санитарно-гигиенического проектирования в фармацевтической отрасли и здравоохранении является предупреждение загрязнения продукции микроорганизмами, частицами и химическими веществами. Каждый из загрязнителей имеет значение, но основное внимание уделяется микробному загрязнению.
2-3/2020 (76-77) март-июнь
- Квалификация передаточных шлюзов (боксов)

Оборудование для передачи материалов играет немаловажную роль в минимизации рисков попадания загрязнений для производственных процессов. Специалист в данной области Хесус Касас рассказывает о доступных на рынке передаточных шлюзах, подробно объясняя как правильно проводить их квалификацию.
- Роботизация и изоляционно-барьерные системы: идеальная комбинация для передовой асептической обработки

Целью передовой асептической обработки является устранение и абсолютный контроль всех источников загрязнения, прежде всего созданных человеком. Для достижения этой цели в дальнейшем основными технологиями будут роботизация и изоляционно-барьерные системы.
- Необходимость разработки единого стандарта по дезинфекции

Для отрасли и производителей дезинфицирующих средств настало время разработать руководство по оценке продукции, предназначенной для применения в чистых помещениях фармацевтических предприятий.
1/2020 (75) январь-февраль
- Асептическая обработка рук

В одном из исследований были найдены участки поверхности рук, которые при антисептической обработке недостаточно смачивались препаратом. Определенные участки рук особенно часто не смачивалисьантисептическим препаратом, например, большие пальцы и кончики пальцев.
- Одежда для чистых помещений: рискориентированный подход

Целостный подход к валидации одежды для чистых помещений требует больших усилий на начальном этапе проектирования и этапе квалификации проекта. Миленко Павичич и Тьерри Вагнер из компании DuPont раскрывают эту тему.
6/2019 (74) ноябрь-декабрь
- Антистатические (ESD) салфетки – все, что нужно знать

ESD-салфетки (ESD - Electrostatic Dissipative) обязательно должны быть в чистом помещении для сборки электроники. Эти салфетки разработаны специально для предотвращения любых электростатических разрядов, способных повредить чувствительные электронные устройства или повлиять на их работу.
5/2019 (73) сентябрь-октябрь
- Спецодежда для чистых помещений: основные концепции

Чистые помещения задуманы как искусственная производственная среда, необходимая для минимизации концентрации загрязняющих веществ в воздухе. С тех пор, как Уиллис Уитфилд установил первое чистое помещение в Национальной лаборатории Сандиа (США) в 1962 году, они претерпели множество усовершенствований. Сегодня чистые помещения играют жизненно важную роль в производственных процессах фармацевтической и микропроцессорной промышленности, а также в других отраслях, где крайне важно контролировать загрязнение воздуха аэрозольными частицами.
- Барьерные системы ограниченного доступа, изоляторы и системы отслеживания

Sola dosis facit venenum (лат.)— «Только доза делает вещество ядом». Так звучит цитата из Парацельса, швейцарского врача, алхимика и астролога, родившегося в 1493 году, человека, которого считают отцом токсикологии. Проблема возникает, когда лекарство, разработанное для лечения, становится прямо противоположным по своему предназначению — ядом.
- Приложение 1 к GMP: Качественное изменение в выборе одежды для чистых помещений

Как объясняет Жан-Франсуа Тенель из компании Дюпон, лидера на рынке медико-биологической отрасли, новый комплекс руководств вынудит производителей изменить подход к контролю загрязнений, в том числе их отношение к одежде для чистых помещений.
4/2019 (72) июль-август
- Нужна ли валидация очистки в лаборатории?

Методы очистки для фармацевтической промышленности разрабатываются и валидируются преимущественно для производственного оборудования. Могут ли такие же методы использоваться в аналитической лаборатории для очистки стеклянной посуды, шлангов и другого инвентаря? И следует ли валидировать также лабораторные методы очистки?
- Обоснование процесса очистки и дезинфекции

Всегда ли перед дезинфекцией необходим отдельный этап очистки? Валид Эль Азаб из компании СТЕРИС объясняет научный подход к выбору метода, уместного для чистых помещений и поверхностей, не контактирующих с продуктом.
2/2017 (62) апрель-июнь
- Опыт применения импульсных ультрафиолетовых установок в комплексе дезинфекционных мероприятий в чистых помещениях

В последние годы, в том числе на страницах данного журнала, специалисты в области проектирования, строительства, оснащения, эксплуатации, контроля и мониторинга чистых помещений активно обсуждают вопрос обеспечения в них микробиологической...
- Маленькие частицы, большие результаты

Для очистки микроструктур применяются многоцелевые ультразвуковые системы
1/2017 (61) январь-март
- Принцип «наихудшего случая» при проведении исследований образования биоплёнки для оценки эффективности процедуры очистки
Исследование, проведенное сотрудниками компании "STERIS", доказывает важность тестирования (с точки зрения эффективности действия) различных химических соединений, которые используются для очистки и дезинфекции поверхностей оборудования и предотвращения образования как типичных, так и нетипичных биопленок
- Использование лучшего опыта в контроле микробиологической загрязненности

Базовое обучение контролю микробиологической загрязненности
- Технология обработки готовых к использованию контейнеров для наполняющих линий небольшой производительности

В своей статье г-н С. Морли, вице-президент компании "Noxilizer", описывает новую технологию биологической очистки внешних поверхностей контейнеров, содержащих готовые к наполнению/использованию одноразовые шприцы при прохождении изолирующего барьера линии наполнения
4/2016 (60) окрябрь-декабрь
- Нежелательные микроорганизмы в нестерильном производстве

Во многих отраслях промышленности при оценке качества продукта особое значение имеет микробиологическая чистота, характеризующаяся общим количеством аэробных микробов и дрожжевых и плесневых грибов, а также наличием специфических микроорганизмов
- Моделирование асептических процессов. Нерешенные вопросы имитации на питательных средах

Еще один взгляд на асептический процесс
3/2016 (59) июль-сентябрь
- Контроль загрязнений. Всесторонний обзор стратегий контроля микробной загрязненности
Скотт является признанным консультантом и тренером в таких областях, как GМР (Надлежащая производственная практика), исследовательская работа, охрана окружающей среды и контроль микробиологической чистоты, а также организация работы и аудит микробиологических лабораторий. - Передовая практика санитарной обработки в фармацевтическом производстве

Статья опубликована в журнале "Cleanroom Technology", февраль 2016
- Защитная одежда для всех непредвиденных обстоятельств
В своей статье автор описывает последние тенденции и достижения в технологиях защиты персонала за 2015 год
2/2016 (58) апрель-июнь
- Производство с использованием изоляторных технологий

Текст к публикации подготовлен специалистами компании ООО «УНИКА инжиниринг» по материалам статьи Хилари Эйшфорд, опубликованной в журнале "Cleanroom Technology", январь 2016 (www.cleanroomtechnology.com)
Создание больших классических чистых помещений предполагает сравнительно большие капиталовложения и достаточно длительное время проведения строительномонтажных работ, поэтому появляется всё больше альтернативных решений в форме систем одноразового использования, таких как усовершенствованные изоляторы, перчаточные боксы и барьерные системы ограниченного доступа (RABS - Restricted Access Barriers Systems). В статье представлен обзор новых разработок в таких системах, реализованных в 2015 году
- Люди в чистых помещениях: Понимание и мониторинг фактора персонала
Статья опубликована на сайте www.ivtnetwork.com - Почему изменения в асептическом производстве неизбежны?

Статья опубликована в журнале «Clean Air & Containment Review», № 25, январь 2016 (www.cleanairandcontainment.com)
- Исследования эффективности дезинфекции обнаруживают сильные и слабые ее стороны

Статья опубликована в журнале "Cleanroom Technology", январь 2016 (www.cleanroomtechnology.com)
Изменения в Приложении 1 ЕU GMP, касающиеся передачи материалов в/из асептические зоны приготовления лекарственных средств, оказало специфическое влияние на методы применения дезинфицирующих средств и испытаний эффективности дезинфекции
- Оптимизация дезинфекции процесса ручной передачи материала в зоны асептического приготовления

Статья опубликована в журнале «Cleanroom Technology», декабрь 2015 (www.cleanroomtechnology.com)
Последние изменения в Правилах GMP привели к изменениям в методах дезинфекции материалов, переносимых в асептическую зону. Карен Росингтон анализирует эти изменения и высказывает некоторые соображения по поводу проведения необходимых испытаний дезинфицирующих средств
- Обеспечение высокой степени изоляции при фильтрации и сушке в процессе производства активных фармацевтических субстанций

Статья опубликована в журнале "Cleanroom Technology", февраль 2016 (www.cleanroomtechnology.com)
Активность лекарственных средств и их субстанций постоянно возрастает, и это требует обеспечения эффективных условий изоляции все большего числа технологических операций при их обращении и производстве. В статье представлен обзор образцов конструкций современного оборудования, отвечающего поставленной цели
1/2016 (57) январь-март
- Революция в очистке

Статья опубликована в журнале «Cleanroom Technology», сентябрь 2015 (www.cleanroomtechnology.com)
Новая альтернативная технология очистки, способная стать недорогим, экологически чистым методом очистки, прошла успешную апробацию в широком спектре областей применения
- Асептическое производство: безопасность под контролем

Статья опубликована в журнале «BioPharm International», 28 (7) 2015
Асептическое производство - зона опасного риска не только для продукта, т.к. люди являются самой серьезной угрозой загрязнения, но и для персонала, в связи со все возрастающей активностью фармацевтических ингредиентов
4/2015 (56) октябрь-декабрь
- Основы очистки и дезинфекции для асептического производственного участка. Валидация дезинфекции

Очистка в фармацевтической отрасли всегда была, есть и будет одним из критических процессов производства лекарственных препаратов. Нужно иметь в виду, что под очисткой в фармацевтической отрасли подразумевают не только удаление механических частиц и микробиологических загрязнений, но и...
- Организация стерильного переодевания в специальных средах

Надлежащий процесс переодевания в стерильную одежду является ключевым фактором контроля загрязнений в асептических технологических процессах.
- Размещение седиментационной пластины в однонаправленном воздушном потоке и влияние потери массы (высыхания агара) на рост микробов

Седиментационные пластины являются важным элементом программы мониторинга состояния окружающей среды и оценки микробной загрязненности внутри чистых зон, в частности, находящихся в устройствах с...
- Усовершенствование методов контроля электростатического разряда

Как оценить результаты применения программы контроля электростатического разряда (ESD-контроля, англ. Electro Static Discharge) в процессе эксплуатации чистых помещений?
3/2015 (55) июль-сентябрь
- Стандарты очистки для обеспечения соответствия требованиям USP 797

Статья опубликована на сайте журнала «Controlled Environments» (www.cemag.us)
Для очистки пола наиболее удачным инструментом служат веревочные швабры из трикотажных прядей с заделанными концами для предотвращения отделения частиц и волокон. Для качественной промывки швабры ее следует часто прополаскивать в двухтрех ведрах. Швабру следует сначала окунуть в «грязное» ведро, прополоскать ее там, а затем отжать. Эту процедуру нужно повторить со вторым (и третьим, если имеется) ведром, чтобы предотвратить повторное загрязнение шваброй. Водный раствор моющего или дезинфицирующего средства в ведре также должен часто меняться, чтобы избежать повторного загрязнения.
- «Путеводитель» по протирочным материалам

Статья опубликована в журнале «Controlled Environments Magazine», май-июнь 2015 (www.cemag.us)
Инспектирующие органы требуют предоставлять результаты испытаний, подтверждающие, что протирочные материалы, поставляемые дистрибьюторами в качестве расходных для чистых помещений, не содержат загрязнений в виде частиц и волокон. Это требование USP797?
- Стерилизация оксидом этилена: планирование в свете будущих регуляторных изменений

Текст к публикации подготовлен специалистами компании ООО «УНИКА инжиниринг» по материалам статьи Сусаны Биркс, опубликованной в журнале «CleanroomTechnology» в мае 2015 года
Использование оксида этилена является весьма популярным методом обеззараживания у производителей изделий медицинского назначения. Тем не менее, производителям необходимо быть в курсе публикаций новых стандартов и регуляторных изменений, чтобы в своей производственной деятельности соответствовать всем нововведениям.
2/2015 (54) апрель-июнь
- Обеззараживание чистых помещений парами перекиси водорода в асептическом производстве

Материал подготовлен компаниями NNE Pharmaplan и Bioquell
- Оценка загрязнения воздуха микрочастицами с помощью новых методов ускоренного микробиологического анализа

Статья опубликована в журнале «European Journal of Parenteral & Pharmaceutical Sciences», № 19 (4), 2014
- Методы определения микроорганизмов в чистых помещениях

Статья опубликована в журнале «Controlled Environments Magazine», январь-февраль 2015
- Протирочные материалы для чистых помещений. Применение в чистых помещениях протирочных материалов, предварительно пропитанных дезинфицирующими средствами

Статья опубликована в журнале European Medical Hygiene, февраль 2015 (www.emhmagazine.com)
1/2015 (53) январь-март
- Теория безразборной (CIP) мойки оборудования

В статье объясняются основные понятия и правила применения безразборной (англ. CIP - Cleaning In Place) мойки производственного оборудования
- Почему важна длина перчаток для чистых помещений
Статья публикуется с разрешения журнала «Cleanroom Technology», ноябрь 2014 (www.cleanroomtechnology.com)Основной функцией перчаток для чистых помещений является защита продукта от загрязнения либо пользователя от воздействия химических веществ. При выборе перчаток следует учитывать множество характеристик, таких как тактильные ощущения, гибкость, наличие антистатических свойств и т.д. Однако одним из важнейших свойств перчаток является их длина. - Открытие Земмельвейса

Когда посетители Венского медицинского музея во время экскурсии останавливаются перед витриной, посвященной Игнацу Филиппу Земмельвейсу, «создателю основ профилактики инфекций у рожениц», то чаще всего задают вопрос: «Какое открытие сделал Земмельвейс?» и всегда получают ответ: «Мытье рук».
- Стандарты гигиенической подготовки персонала
Безопасность продукции, процессов ее изготовления, хранения, перевозки и реализации предполагает состояние, при котором ответственные лица осознают потенциальные угрозы, могут их держать под контролем и исключают возможность реализации недопустимого риска для потребителя. - Мониторинг контролируемой среды: использование контактных чашек для количественного определения жизнеспособных микроорганизмов в воздушной среде

Статья опубликована на сайте журнала «Controlled Environments», (www.cemag.us)
- Эффективное применение дезинфицирующих средств

Статья опубликована на сайте журнала «Controlled Environments», (www.cemag.us)
- Перспективы мониторинга загрязнений воздушной среды летучими молекулярными соединениями
Статья публикуется с разрешения журнала «Cleanroom Technology», май 2014 (www.cleanroomtechnology.com)Загрязнение воздушной среды летучими молекулярными соединениями является одной из наиболее распространенных проблем в сфере производства полупроводниковой, фотоэлектрической и светодиодной продукции, однако технологии мониторинга и измерения этих загрязнений часто отстают от развивающихся технологий производственных процессов. Настоящий исследовательский проект ЕС позволит коренным образом изменить ситуацию. - Преимущества проведения микробиологического мониторинга в реальном масштабе времени

Статья опубликована на сайте журнала «Controlled Environments» (www.cemag.us)
4/2014 (52) октябрь-декабрь
- Преимущества применения одноразовых систем в фармацевтическом производстве

Наиболее распространенным материалом для ограждающих конструкций и локализации чистых зон в фармацевтическом производстве традиционно считалась нержавеющая сталь, однако в последнее время все активнее стали использоваться одноразовые системы изоляции.
- Изоляционные технологии для лабораторий регенерации тканей

В связи с ростом интереса к регенеративной медицине все больше компаний стремятся расширить свою деятельность в этой области. Массимильяно Цезарини из компании «Comecer Group» описывает процесс переоснащения лаборатории регенерации тканей с помощью изоляционных технологий в целях повышения уровня стерильности и снижения производственных затрат
- Повышение уровня безопасности в процессе дезинфекции поверхностей

Регулярная дезинфекция поверхности пола является неотъемлемым элементом работы в чистом помещении, однако подобные ручные процессы с трудом поддаются валидации. Маргарет Витт-Мэкель и Дитмар Пфенниг делятся советами по использованию специального оборудования
- Новый акцент GMP на предотвращении перекрестного загрязнения

Из выступления на конференции «Обеспечение качества лекарственных средств 2014» (www.pharma-quality.org)
3/2014 (51) июль-сентябрь
- Единое технологическое решение для изготовления асептических и высокоактивных препаратов

Статья публикуется с разрешения редакции журнала Cleanroom Technology, февраль 2014 (www.deanroom-technology.co.uk)
В этой статье представлены некоторые проблемы, связанным с оборудованием для производства асептических и высокоактивных препаратов, а также пути их возможного решения
- Прерывание цепной передачи инфекции

Статья публикуется с разрешения редакции журнала Cleanroom Technology, май 2013 (www.cleanroom-technology.co.uk
Одежда медицинских работников является одним из ключевых факторов, способствующих прерыванию цепной передачи инфекции. Сотрудники Института Хоенштайн тщательно изучили эту проблему и пути ее решения
- Разработка тканей, снижающих распространение вирусов

Учёные из Hohenstein Institute (Германия) впервые разработали ткань, сочетающую антивирусные и антибактериальные свойства
2/2014 (50) апрель-июнь
- Энергосберегающий материал для воздушных фильтров

Статья публикуется с разрешения редакции журнала Cleanroom Technology, октябрь 2012 (www.cleanroom-technology.co.uk)
- Что означают символы на упаковках перчаток

Статья публикуется с разрешения редакции журнала Cleanroom Technology, август 2011 (www.cleanroom-technology.co.uk)
- Одежда для чистых помещений

Статья публикуется с разрешения редакции журнала Cleanroom Technology, ноябрь 2010 (www.cleanroom-technology.co.uk)
Производитель и поставщик расходных материалов и одежды для чистых помещений компания Nitritex недавно начала предоставлять услуги прачечной.
1/2014 (49) январь-март
- Планирование процессов стерилизации этиленоксидом

Опубликовано по материалам сайта www.sordellini.com
Представленный в этой статье структурированный метод позволит инженерам-технологам спланировать и валидировать безопасный и эффективный цикл стерилизации этиленоксидом (Еto). Читатель несомненно получит исчерпывающую информацию по его проведению
- Оптимальные условия испытания на бионагрузку для фармацевтических процессов: анализ практического примера

Статья опубликована в журнале European Journal of Parenteral and Pharmaceutical Sciences, том 18 № 3
- Механизмы бактериальной адгезии

Опубликовано по материалам сайта www.ivtnetwork.com
4/2013 (48) октябрь-декабрь
- Определение допустимых пределов содержания видимых остатков на поверхностях производственного фармацевтического оборудования

В ходе описанного исследования были проанализированы показатели минимального поддающегося визуальному определению количества остаточных веществ, т.е. допустимого предела содержания видимых остаточных веществ (VRL-visible residue limits), для небольшого числа активных фармацевтических ингредиентов (АФИ), а также ...
- Системы гигиенического мониторинга текстиля

Технология контроля микрозагрязнений в системе здравоохранения начала внедряться, прежде всего, в операционных палатах, палатах интенсивной терапии и лабораториях.
- Показатели качества текстильных материалов для одежды чистых помещений

По материалам документа IEST-РР-СС003.4 - Рекомендуемая практика «Рассмотрение системы одежды для чистых помещений и других контролируемых сред»
3/2013 (47) июль-сентябрь
- Положительный результат испытания на стерильность: что делать дальше?

Статья опубликована в журнале Pharmaceutical Outsourcing, январь 2013 года, и печатается с сокращениями
- Основы асептических процессов Интервью

Рэй О'Коннор, консультант производственного отдела Национального института исследования биотехнологий и подготовки кадров (NIBRT), рассказывает об основах проектирования и функционирования биофармацевтических предприятий.
- Автоматизированная идентификация микроорганизмов: сравнение подходов Фармакопеи США и Европейской Фармакопеи

Идентификация микроорганизмов имеет большое значение в фармацевтическом производстве. Идентификация микроорганизмов может быть определена как «оценка микроорганизмов путем проведения ограниченного набора предварительно отобранных в соответствии с исследуемым вопросом испытаний».
- Новая версия Руководства для разработчиков, производителей и пользователей одежды для чистых помещений

Настоящей публикацией мы продолжаем анализ последней версии документа IEST-RP-CC003.4 «Рассмотрение системы одежды для чистых помещений и других контролируемых сред» (2011г.), так называемого Рекомендуемой Практики (RP)...
2/2013 (46) апрель-июнь
- Новая версия руководства для разработчиков, производителей и пользователей одежды для чистых помещений

В последнюю четверть века круг и количество производителей, которые производят свои изделия в чистых производственных помещениях, значительно расширились. Прежде всего, это связано с внедрением высоких технологий.
- Методы валидации очистки посредством измерения содержания углерода

Сравнение метода прямого сжигания с методами анализа проб промывной воды и воды, экстрагируемой из протирочных тампонов.
- Характеристика и контроль микробного сообщества на поверхности теплообменников систем отопления, вентиляции и кондиционирования воздуха (HVAC)

Рост числа микроорганизмов в системах отопления, вентиляции и кондиционирования воздуха (HVAC), вызывающее последующее загрязнение воздушной среды в чистом помещении, становится все более актуальной проблемой.
- Очистка чистых помещений

Статья печатается с разрешения журнала Controlled Environments, September 2012 (www.cemag.us)
1/2013 (45) январь-март
- Результативная (эффективная) протирка

Влажные салфетки являются эффективным средством очистки для чистых помещений, однако, при неправильном их использовании время, потраченное на тестирование и валидацию таких салфеток, окажется потраченным впустую. Карен Россингтон рассматривает научные основы, скрывающиеся за процессом эффективной протирки.
- Не забывайте про одежду

Чтобы эффективно исполнять свою роль в контроле загрязнений окружающей среды, технологическая одежда для чистых помещений должна удовлетворять нескольким критериям. Ульрик Костер и Стив Марнач из компании DuPont Personal Protection рассматривают комбинацию требований к одежде по защите персонала и продукции
- Проблемы выбора биоцидов

В предлагаемой Вашему вниманию статье доктор Кэтрин Стейнхауэр рассматривает применение европейских норм по испытанию дезинфектантов в рамках рекомендаций Федерального Управления по контролю качества пищевых продуктов и лекарственных средств США (FDA) для фармацевтической промышленности
- Контроль загрязнений «под башмаком»

This article was published in the July/August 2012 issue of Controlled Environments magazine, pp. 10-13
- Контроль биозагрязнений

Семинар, организованный компанией Isotron был адресован целому ряду пользователей чистых помещений, от производителей изделий медицинского назначения, до производителей комплектующих изделий и компаний, занимающихся упаковкой по контракту.
4/2012 (44) октябрь-декабрь
- Дезинфекция ультрафиолетовым излучением материалов для упаковки пищевой продукции

Ультрафиолетовое излучение уже используется в целях дезинфекции воды и в системах кондиционирования воздуха. Статья объясняет, каким образом ультрафиолетовое излучение также является эффективным и экономичным решением для дезинфекции упаковочных материалов для пищевых продуктов
- Выбор подходящих протирочных материалов

При большом количестве протирочных материалов, предлагаемых на рынке, выбор подходящего продукта для конкретного применения становится сложной задачей. Карен Россингтон рассматривает основные положения, которые необходимо учитывать при правильном выборе нужного вида протирочных материалов и их наилучшем использовании.
- Квалификация средств для очистки поверхности

Чтобы поддерживать микробиологический контроль чистых помещений на фармацевтических производствах, все поверхности следует подвергать обработке при помощи подходящих дезинфицирующих средств...
- Выбор перчаток

Выбор типа одноразовых перчаток для конкретного процесса - весьма сложная задача. Статья рассматривает возможные варианты, лимитирующие факторы и документы, обеспечивающие выполнение требований, необходимых для чистых помещений.
3/2012 (43) июль-сентябрь
- Изоляторы в фармацевтическом производстве. Приемка оборудования и выбор материалов

Изоляторы и различного рода барьерные устройства находят все большее распространение в фармацевтической, микробиологической, атомной и других областях промышленности в связи с тем, что они могут обеспечить защиту продукта от загрязнений, защиту персонала от токсичных материалов, а также то и другое вместе.
1/2012 (41) январь-март
- Статистическое обоснование пределов количественного определения для остатков веществ при визуальной оценке чистоты поверхности

Оценка чистоты поверхностей с помощью визуального осмотра широко применяется при оценке уровня загрязнения поверхностей.
- Руководящие указания по инспектированию валидации процессов очистки

Валидация очистки вызвала активное обсуждение после того, как этот вопрос был кратко затронут в документах FDA, включая руководящие указания по инспектированию химических фармацевтических субстанций и руководящие указания по инспектированию биотехнологических производств.
- Знакомство с перчаточными боксами

Перчаточный бокс - это устройство с контролируемой воздушной средой, представляющее собой камеру, манипуляции внутри которой осуществляются при помощи длинных рукавиц из непроницаемого материала.
- Преимущества изолирующих устройств и асептической технологии

Учитывая возрастающую потребность в асептическом производстве и изготовлении сильнодействующих препаратов, изоляторы получают все более широкое применение.
4/2011 (40) октябрь-декабрь
- Как работать в чистых помещениях с препаратами, имеющими высокие коллоидные и микробиологические нагрузки

Как правило, в фармпроизводствах высокочистые помещения предназначены для финальных стадий производства готовых лекарственных форм. При этом уровень чистоты компонентов препаратов относительно высок.
- Электростатическая безопасность чистых производственных помещений

Вопросы, относящиеся к защите от статического электричества в чистых производственных помещениях (ЧП), возникли и остаются актуальными с самого начала их эксплуатации, т.е. более 60 лет.
- Липкие коврики в фармацевтическом производстве

Чистота в фармацевтическом производстве является одним из ключевых факторов, обеспечивающих соблюдение требований GMP. Основные загрязнения - механические частицы, на поверхности которых удерживаются микроорганизмы, - могут попадать в чистое помещение из разных источников, в том числе и с подошв персонала и роликов тележек с материалами.
- Активная виброизоляция для высокочувствительного измерительного оборудования

Активная виброизоляция позволяет добиться очень низкого остаточного уровня вибрации, особенно для низкочастотных возмущений, при этом отсутствуют резонансные явления, имеющие место в пассивных системах...
- Защита от вибраций, возбуждаемых в зданиях и сооружениях

Наноисследования включают измерения, манипуляции и сборку изделий на самом мельчайшем уровне. Точность выполнения задач, критичная для исследований в наномасштабах, требует «спокойной» обстановки.
3/2011 (39) июль-сентябрь
- Работаем с углем по-умному!

Использование активированного угля даже в чистых помещениях без проблем и грязи!
- Технологии очистки для производства электроники

Частицы, остатки флюса, технологические среды, отпечатки пальцев - все это представляет собой мельчайшие элементы, которые могут серьёзно повредить или вывести из строя электронные устройства.
- Разделительные устройства с очисткой воздуха и изолированные зоны

Разделительные устройства с очисткой воздуха используются в критических зонах чистых помещений с целью обеспечения наивысшего качества воздушной среды (и в некоторых типах устройств - для предотвращения контакта с персоналом).
1/2011 (37) январь-март
- Почему тампон имеет значение при валидации очистки

Управление США по надзору за качеством пищевых продуктов и лекарственных средств (FDA) издало в 1993 г. документ - «Руководство по проведению инспекций -Валидация процессов очистки» [1].
- Основы очистки изоляторов

В связи с возросшим числом манипуляций с опасными фармацевтическими ингредиентами, а также потребностью в мелкосерийном производстве и гибком технологическом оборудовании на фармацевтических производствах все шире используются изоляторы.
- Воздушные души

Статья предоставляет читателю возможность ознакомиться с одним из способов увеличения продуктивности и уменьшения эксплуатационных затрат чистых производственных помещений
4/2010 (36) октябрь-декабрь
- Валидация очистки медицинских изделий

Остаточные загрязнения поверхности медицинских изделий могут приводить к отторжению имплантата и плохой работе самого изделия.
3/2010 (35) июль-сентябрь
- Автоматическое обеззараживание поступающих компонентов в материальном шлюзе

Неуклонное повышение качества фармацевтического производства и требований по поддерживанию чистоты окружающей среды и производственных процессов является долговременной тенденцией, которая постоянно служит источником новых идей и методов достижения поставленной цели.
- Использование стерильной технологической одежды минимизирует риск загрязнений

Жесткое требование соблюдения чистоты и стерильности в чистых помещениях является приоритетной задачей в таких связанных с медициной и биологией отраслях как фармацевтическое производство.
2/2010 (34) апрель-июнь
- Дезинфекция начинается с правильного выбора средств

Чтобы понять, какое дезинфицирующее средство будет наиболее эффективным в вашей ситуации, нужно обратиться к основам
- Оценка рисков микробного загрязнения при эксплуатации «чистых» помещений

Источником появления микробного загрязнения в чистых помещениях являются технологические среды (воздух, вода, инертные газы), персонал, поступающее сырье и материалы, используемое оборудование и неэффективная санитарная подготовка.













